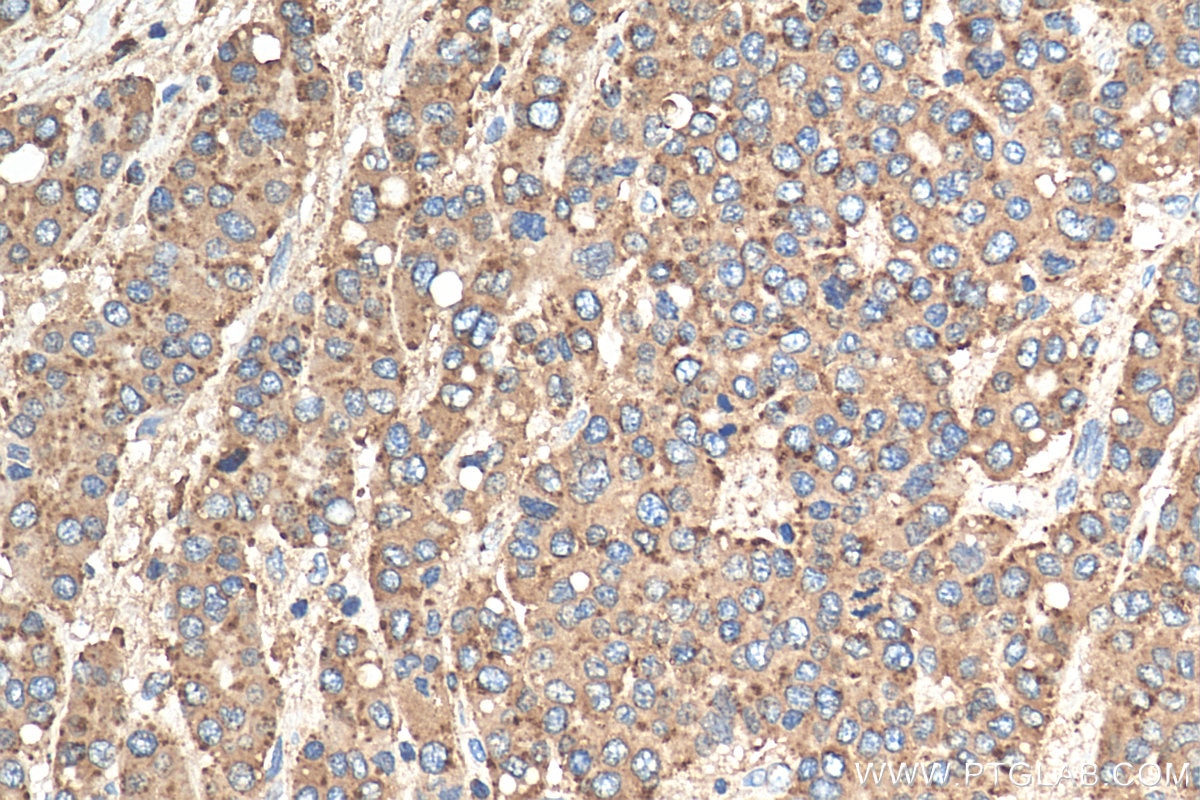
Immunohistochemistry (IHC) staining of human liver cancer tissue using CD107a / LAMP1 Polyclonal antibody (21997-1-AP)

Tested Applications
| Positive WB detected in | HepG2 cells, HEK-293 cells, L02 cells, MCF-7 cells, MDA-MB-231 cells, U-937 cells |
| Positive IHC detected in | human liver cancer tissue, human colon cancer tissue, human gliomas tissue, human pancreas tissue, human placenta tissue Note: suggested antigen retrieval with TE buffer pH 9.0; (*) Alternatively, antigen retrieval may be performed with citrate buffer pH 6.0 |
| Positive IF-P detected in | human ovary tumor tissue |
Recommended dilution
| Application | Dilution |
|---|---|
| Western Blot (WB) | WB : 1:5000-1:50000 |
| Immunohistochemistry (IHC) | IHC : 1:300-1:1200 |
| Immunofluorescence (IF)-P | IF-P : 1:50-1:500 |
| It is recommended that this reagent should be titrated in each testing system to obtain optimal results. | |
| Sample-dependent, Check data in validation data gallery. | |
Published Applications
| WB | See 107 publications below |
| IHC | See 7 publications below |
| IF | See 1 publications below |
| IP | See 2 publications below |
| CoIP | See 1 publications below |
Product Information
21997-1-AP targets CD107a / LAMP1 in WB, IHC, IF-P, IP, CoIP, ELISA applications and shows reactivity with human samples.
| Tested Reactivity | human |
| Cited Reactivity | human, pig, monkey, zebrafish, bovine, turtle |
| Host / Isotype | Rabbit / IgG |
| Class | Polyclonal |
| Type | Antibody |
| Immunogen |
CatNo: Ag17367 Product name: Recombinant human CD107a protein Source: e coli.-derived, PGEX-4T Tag: GST Domain: 35-377 aa of BC021288 Sequence: NGNGTACIMANFSAAFSVNYDTKSGPKNMTFDLPSDATVVLNRSSCGKENTSDPSLVIAFGRGHTLTLNFTRNATRYSVQLMSFVYNLSDTHLFPNASSKEIKTVESITDIRADIDKKYRCVSGTQVHMNNVTVTLHDATIQAYLSNSSFSRGETRCEQDRPSPTTAPPAPPSPSPSPVPKSPSVDKYNVSGTNGTCLLASMGLQLNLTYERKDNTTVTRLLNINPNKTSASGSCGAHLVTLELHSEGTTVLLFQFGMNASSSRFFLQGIQLNTILPDARDPAFKAANGSLRALQATVGNSYKCNAEEHVRVTKAFSVNIFKVWVQAFKVEGGQFGSVEECLL Predict reactive species |
| Full Name | lysosomal-associated membrane protein 1 |
| Calculated Molecular Weight | 45 kDa |
| Observed Molecular Weight | 90-120 kDa |
| GenBank Accession Number | BC021288 |
| Gene Symbol | LAMP1 |
| Gene ID (NCBI) | 3916 |
| ENSEMBL Gene ID | ENSG00000185896 |
| RRID | AB_2878966 |
| Conjugate | Unconjugated |
| Form | Liquid |
| Purification Method | Antigen affinity purification |
| UNIPROT ID | P11279 |
| Storage Buffer | PBS with 0.02% sodium azide and 50% glycerol, pH 7.3. |
| Storage Conditions | Store at -20°C. Stable for one year after shipment. Aliquoting is unnecessary for -20oC storage. 20ul sizes contain 0.1% BSA. |
Background Information
LAMP1 (also known as CD107a) is a 90-120 kDa heavily glycosylated membrane protein enriched in the lysosomal membrane. LAMP1 functions to provide selectins with carbohydrate ligands. This protein has also been shown to be a marker of degranulation on lymphocytes such as CD8+ and NK cells and may also play a role in tumor cell differentiation and metastasis.
Protocols
| Product Specific Protocols | |
|---|---|
| IF protocol for CD107a / LAMP1 antibody 21997-1-AP | Download protocol |
| IHC protocol for CD107a / LAMP1 antibody 21997-1-AP | Download protocol |
| WB protocol for CD107a / LAMP1 antibody 21997-1-AP | Download protocol |
| Standard Protocols | |
|---|---|
| Click here to view our Standard Protocols |
Publications
| Species | Application | Title |
|---|---|---|
Immunity The Endotoxin Delivery Protein HMGB1 Mediates Caspase-11-Dependent Lethality in Sepsis. | ||
Adv Sci (Weinh) Inhibition of CK2/ING4 Pathway Facilitates Non-Small Cell Lung Cancer Immunotherapy | ||
Adv Sci (Weinh) OTUD5 Protects Dopaminergic Neurons by Promoting the Degradation of α-Synuclein in Parkinson's Disease Model | ||
Arthritis Rheumatol LAMP3 induces lysosome-dependent cell death by impairing autophagic caspase-8 degradation in Sjögren's salivary glands | ||
Mol Ther Polyphyllin D "Punctures" Hypertrophic Lysosomes to Reverse Drug Resistance of Hepatocellular Carcinoma by Targeting Acid Sphingomyelinase | ||
Nat Commun Mismatch repair deficiency predicts response to HER2 blockade in HER2-negative breast cancer. |
Reviews
The reviews below have been submitted by verified Proteintech customers who received an incentive for providing their feedback.
FH Zakia (Verified Customer) (05-22-2024) | Works great.
|
FH Marina (Verified Customer) (08-08-2022) | Western blot against LAMP1 in human breast cancer cell line HCC1937. 1:1000 dilution, overnight incubation at 4ºC. A clear band can be observed between 95 and 130 kDa. Ponceau S staining is included as total protein loading control.
 |
FH Azita (Verified Customer) (06-17-2021) | Immunocytochemistry labelling of (4% PFA) fixed NSC-34 cells by LAMP1 Polyclonal antibody at dilution of 1:50 showed strong labelling.
|
FH Mayru (Verified Customer) (04-30-2019) | The antibody works great for detection of LAMP1 protein expression using Western blot analysis.
|